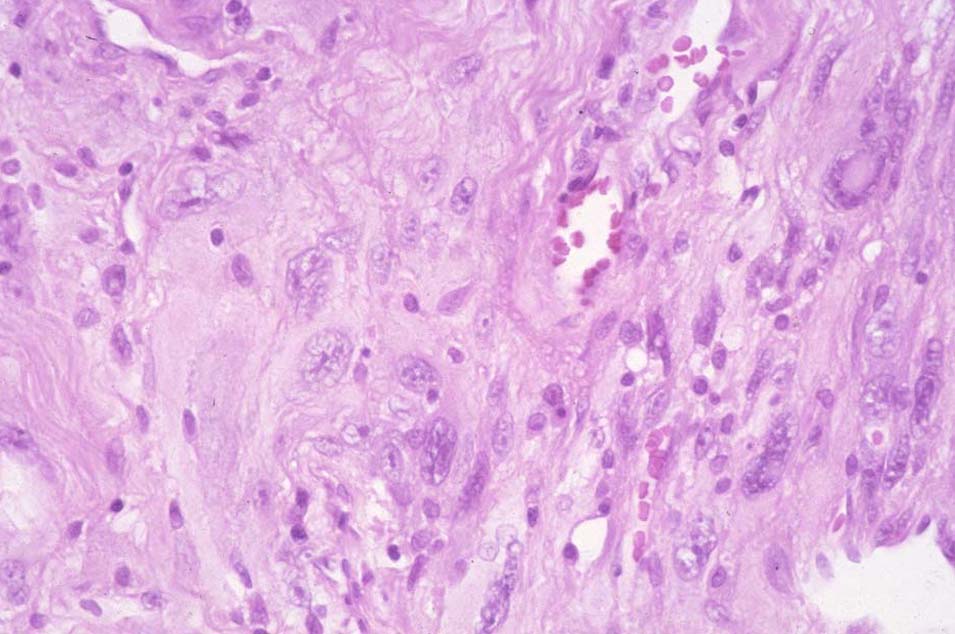
MFH-pleomorphic UCSF collection

Soft Tissue Sarcomas
Epidemiology
Soft Tissue sarcomas are less than 1% of all malignancies in the US. They occur at any age and are more common in older patients. 15% are younger than age 16 and 40% older than age 55. There are about 8300 new cases and 3900 deaths per year.
- 8300 - 10,400 new cases / year; 3900 deaths/year
- Median age 40 - 60 years
- Genetics:
- NF-1
- Retinoblastoma
- Gardiner's Syndrome -- FAP (ad APC mutation 5q21)
- Li-Fraumeni Syndrome
- Environmental Exposures to:
- ionizing radiation
- herbicides
- thorotrast (α emitter w/ biologic t1/2 = 22 years)
- vinyl chloride
- arsenic
- chlorophenols
- Lower Extremity 45% > Trunk (30%) > upper extremity 15% > head and neck
- Lower Extremity Diseases:
- liposarcoma
- MFH
- synovial
- fibrosarcoma
- myxoid liposarcoma -- upper medial thigh
- Retroperitoneal Diseases:
- liposarcoma (fewer distant mets)
- leiomyosarcoma (more distant mets
- Head and Neck:
- MHF: usually high grade except myxoid MFH
- Frequency:
- MFH 20-30 %
- liposarcoma 10-20%
- leiomyosarcoma 10-15%
- fibrosarcoma 5-10%
- synovial cell sarcoma 5-10%
- rhabdomyosarcoma 5-10%
- malignant schwannoma/MPNST 5%
- Synovial sarcomas are usally high grade and near but not in joints in tendon sheaths, bursae and joint capsules
- Grade based on: cellularity, differentiation, pleomorphism, necrosis, number of mitoses
Etiology
Etiology is unknown but trauma or injuries are frequently seen in the development of sarcomas. Rare cases arise from scar tissue following surgery, burns or foreign body implantation. Lymphangiosarcomas are observed in lymphedema of the arm (Stewart-Treves Syndrome) following breast cancer treatment. A population stude (Olsson) showed a reduced risk in long term (> 2 years) of oral hormonal birth control use. Desmoids have been shown to express estrogen receptors.
Prior radiation exposure has been related ot the development of soft tissue and bone sarcomas. The interval between radiation and tumor development ranges from 2 to 25 years. The frequency of sarcoma development increases with higher dose and longer follow-up. The rate of radiation induced sarcoma was reported to be 0.2%. Chemotherapy may increase this rate. A population based study of 274,245 breast cancer patients showed that breast RT had a higher risk of developing soft tissue sarcoma than those not treated with an incidence of 0.24 with RT v. 0.14 without radiation at 15 years.
The most common radiation related soft tissue sarcoma is pleomorphic undifferentiated sarcoma (MFH), followed by angiosarcoma, fibrosarcoma and malignant nerve sheath tumor. (Note: The most common sarcoma was osteosarcoma, but MFH was the most common soft tissue sarcoma in a study of 160 patients with 11 presenting with secondary tumor).
Subsequent tumor survival was not affected by site, latency, initial radiation dose, or chemotherapy . Thre factors were demonstrated which did have unfavorable association:
- presentation with metastases
- incomplete or no resection
- tumor size > 5 cm
- Note: tumor grade was not significant.
Radiation induced sarcomas tend to originate close to the penumbra of radiotherapy fields. Theoretically, this may be due to incomplete damage in normal tissues with mutagenic changes which can result in disorganized repair and proliferation, ultimately resulting in tumorogenesis.
In population studies of breast cancer treatment in Sweden 116 soft tissue sarcomas were found in 122,991 women with breast cancer treated between 1958 -- 1992. 40 were angiosarcomas and 76 were other sarcomas. Angiosarcoma correlated with lymphedema (Stewart-Treves) with a relative risk of 9.5, but not radiation therapy. The rate in this population was < 0.1 %. Angiosarcomas are not included in this population since they are associated with lymphedema occur outside the radiation field.
Several chemotoxins have been associated with hepatic-angiosarcomas: Thortrast, vinyl chloride and arsenic solution.
Genetics
Li-Fraumeni Syndrome:
- germ line p53 abnormalities identified.
- familial cluster of sarcomas, early breast cancers, brain tumors, leukemia and adrenal carcinomas.
- NF-1 (chromosome 17)
- Cafe au lait spots
- multiple neurofibromas
- classically likned to the development of soft tissue tumors.
- malignant peripheral nerve sheath tumors arise from malignant degeneration of neurofibromas in 1 - 5 % of cases
Genetic transcription profiling has identified 5 distinct sarcoma groups:
- Synovial sarcomas
- GIST
- Benign peripheral nerve sheath tumors
- half of the leiomyosarcomas
- MFH, liposarcomas and the remaining leiomyosarcomas.
c-KIT and protein kinase C are highly expressed in GIST as is EGFR in synovial sarcoma suggesting that molecular targeting may have a role in future treatment.
Anatomy and Natural History
Soft tissue sarcomas can arise in any soft tissues of the body. Soft tissue structures consist of those tissues derived from primitive mesenchyme of the mesoderm and neruoectoderm. These tissues are muscles, fat, fibrous tissues, blood vessels and supprting structures of the peripheral nervous system. the majority are found in the lower extremeties (45%) followed by trunk (17%) and upper extremety (14%) followed by retroperitoneum and head and neck.
Pathology
MFH (New WHO designation: pleomorphic undifferentiated sarcoma (PUS) ) and liposarcoma are the most common soft tissue neoplasms in adults. The three most common subtypes are: MFH: 26%, lipsarcoma: 18% and leiomyosarcoma 15%.
The histology is dependent on the anatomic sites.
| Extremities: | Liposarcoma, MFH, synovial sarcoma and fibrosarcoma |
| Retroperitoneum: | well differentiated and dedifferentiated lipsarcoma, leiomyosarcoma |
| Visceral: | GIST |
Malignant Fibrous Histiocytoma
MFH is considered the most common soft tissue sarcoma in adults. It is heterogeneous group of sarcomas and sometimes felt to be a poorly differentiated sarcoma. The most common source was myxofibrosarcoma and leiomyosarcoma suggested by analysis by Fletcher. Myogenic sarcomas had a worse prognosis than non-myogenic sarcomas.
![]() |
Histology is inadequate for predicting clinical outcomes. Grading and staging are key to accurate prognosis and treatment of sarcomas. With histologic grading, most soft tissue sarcomas have common biologic behaviors irrespective of histologic type. Grading is a function of the following histologic features:
- degree of cellularity and pleomorphism
- abundance of stroma
- expansile or invasive growth
- extent of differentiation
- mitotic activity
- amount of necrosis
Necrosis and mitotic activity are the most significant prognostic factors in predicting survival and time to distant metastases. The two most favored grading systems are the FNCLCC (French) and NCI.
Leiomyosarcomas
Leiomyosarcomas are the most common GU sarcoma in adults. These tumors arise in the bladder, kidney or prostate in older individuals.
Uterine Sarcomas
Uterine sarcomas are of three major types:
- leiomyosarcomas of the myometrium
- mesodermal mixed tumors (MMMT)
- endometrial stromal tumors (very aggressive behavior)
Gastrointestinal Stromal Tumors
GIST are mesenchymal neoplasms showing differentiation toward interstitial cells of Cajal and are characterized by KIT TK-receptors. GIST tend to recur intra-abdominally including liver metastases.
Desmoid Tumors
Desmoid tumors are a group of clinically diverse, deep seated fibrous neoplasms. Bilogically, there are three main groups:
- sporadic
- Associated with FAP (familial adenomatous polyposis, a subset of Gardiner's Syndrome).
- Multi-centric/familial
Desmoid tumors are slow growing tumors that arise at any site. 60% are extra-abdominal, 25% in the abdominal wall and 15% are intra-abdominal. Site affects management, but it is unclear if site distinguishes biologic differences. Aggressive fibromatosis describes lesion especially retroperitoneum due to potential for invasion and progression. Desmoids do not metastasize, but form large infiltrative masses that recur repeatedly if not widely excised. Wide excision must be balanced with preservation of organ function. Desmoids may be controlled with low dose chemotherapy or NSAIDS and occasionally regress spontaneously.
Gardiner's syndrome/FAP includes abdominal and retroperitoneal desmoids, fibromas, osteomas and epidermoid cysts. There are gentic linkages to the APC gene on Chr. 5.
Fibrosarcoma
Unommon in adults. These tumors usually occur on the trunk or thigh and have a herringbone pattern.
Fibrous Histiocytoma
benign tumors presenting as solitary slow growing nodules. Histiologically cartwheel pattern.
Xanthoma
Lipid laden histiocytes seen with hyperlipidemia. They generally occur in cutaneous or subcutaneous locations. Probably reactive lesions.
Dermatofibrosarcoma Protuberans
Low grade sarcoma, which recurs locally but rarely metastasiczes. It is a spindle cell lesion involving dermis and subcutis. They occur anywhere but more than 50% are on the trunk, 30% on the extremities and 20% on the head and neck. Growth is slow and persistent, enlarging over many years until it becomes protuberant. Large lesions are associated with satellite nodules. With aggressive resection the recurrence is ≤ 5%. With simple excision, up to 50% recur. Rarely fibrosarcomas arise and can metastasize to the lung. These lesions may ultimately lead to amputation or death due to extensive invasion. Bednar's tumor is a variant with melanin pigmentation.
Tumors of the Adipose Tissue
Liposarcoma
Liposarcoma is primarily a tumor of adults. The peak incidence is between 50 and 65 years and accounts for at least 20% of all soft tissue sarcomas in adults. It may occur anywhere bu tthe most common sites are thigh and retroperitoneum. There are three principle forms:
- Atypical lipomatous tumor (ALT)
- Myxoid - round cell
- pleomorphic
ALT-WD liposarcomas are low grade locally aggressive, nonmetastasizing, mesenchymal neoplasms composed of a mature adipocytic profliferations. They present as a deep seated painless enlarging mass that can slowly grow to a very large size. ALT-WD sarcomas are adipocytic, sclerosing, inflammatory or spindle cell types.
Myxoid liposarcoma
This liposarcoma accounts for about 40% of all liposarcomas. The tumor consists of ocal to round primitive non-lipogenic mesenchymal cells and small signet ring lipoblasts in a myxoid stroma. They usually occur deep in sofft tissues of the extremeties and > 66% arise in the thigh. High histologic grade (considered more than 5% round cell component), predicts worse outcome.
Pure myxoid lipsarcomas (ie no round cell component) are associated with OS-5 of 90%. Non round cell myxoid liposarcomas are considered low grade. If more than 5% round cell component is seen, these are considered high grade and the OS-5 is 50%.
Myxoid-round cell variants tend to metastasize to unusual soft tissue or bone locations. Myxoid-round cell variant has t(12;16)(q13-14;p11) translocation and leads to TLS-CHOP fusion. TLS-CHOP protein is highly specific for myxoid-round cell variant.
Myxoid-round cell lesions tend to metastasize to bone and unusual soft tissue (ie non-lung) locations. They can have synchronous or metachronous spread to fat pad areas in the retroperitoneum and axilla in the absence of lung metastases.
Myxoid-round cell variants have an extraordinarily high response rate to radiation compared with more typical soft tissue sarcomas.
Pleomorphic Liposarcoma
Pleomorphic liposarcoma is a high grade highly malignant sarcoma containing a variable number of pleomorphic lipoblasts with high mitotic activity. Clinically the metastasize early to lung with rapid progression of disease and mortality within a short time..
Tumors of the Smooth Muscle
Leiomyosarcoma
These tumors are composed of cells showing smooth muscle features. They arise from any location, but most are in teh retroperitoneal or intrabdomonal sites. They are most common in the uterus. Mitotic activity along with location and size are the best prognostic indicators. These are considered high grade tumors. Complete excision is the therapy of choice.
Skeletal Muscle Tumors -- Rhabdomyosarcomas
There are a variety of Rhabdomyosarcomas: embryonal and alveolar.
Embroyonal/Botryoid
Embryonal rhabdomyosarcomas are small cell tumors showing histologic features of skeletal muscle. Botryoid variant of embryonal rhabdomyosarcoma frequently originates in the mucosa lined visceral organs (vagina). They can also arise in the orbit. These tumors are considered favorable variants in pediatric sarcomas.These tumors are very chemo-sensitive and radio-sensitive and they can disseminate widely. Age is an adverse prognostic indicator and these tumors can arise in adults with worse outcomes.
Alveolar Rhabdomyosarcoma
Alveolar rhabdomyosarcomas occur more ofen in the extremities of young adults. Cytologically they resemble lymphomas and consist of small round blue cells with loss of central cohesion and the formation of irregular "alveolar" spaces. Aleveolar rhabdomyosarcomas are considered "unfavorable" tumors in pediatric cases due to the fact that they are aggressive and carry a worse prognosis than embryonal rhabdomyosarcomas. In adults, there is no difference in prognosis.
Pleomorphic Rhabdomyosarcoma
This is the most common rhabdomyosarcoma in adults, with very poor prognosis: 74% died in one series.
Vascular Tumors
Angiosarcomas
Angiosarcomas arise in either blood vessels or lymphatics. Stewart-Treves syndrome is a lymphangiosarcoma arising i the setting of chronic lymphedema, often secondary to breast cancer treatement. Hemangiosarcomas are found in the skin and superficial soft tissue. Multicentric angiosarcomas occur on the scalp and face of elderly men. Progression can cause severe ulceration and infection. Angiosarcoma of the breast is usually aggressive and recurs locally as well as metastasizing to the lung. Histologic grade has prognostic significance. Angiosarcomas are known to occur in sites of prior radiation and chronic lymphedema. In women who have had prior pelvic irradiation, soft tissue angiosarcomas with epitheliod features in the absence of lymphedema have been noted. These tumors are transiently sensitive to anthracycline and taxane based chemotherapy.
Perivascular Tumors
Glomus Tumor
Glomus tumors are rare benign vascular tumors They are commonly found in the hand. They can cause significant pain. Local and complete excision is the appropriate treatment.
Synovial Tissue Tumors
Nodular Tenosynovitis
Giant cell tumors that occur at any age, but commonly between 30 and 50, they are somewhat more common in women, with greatest frequency in the hand. They are also seen in the ankles and knees. They are slow growing, circumscribed lobulated masses usually diagnosed at < 5 cm. Excision is frequently to close margins with local recurrence rates of 10 - 20%. A diffuse form occurs in and around joints, especially knees and ankles. This neoplams grows in expansive sheets without a mature capsule.
Treatment is primarily surgical, however multiply recurrent lesions which threaten limb integrity can be controlled with radiation in both tendon sheath and intra-articular variants. Radiation should be reserved for locally advanced disease with bone or neurovascular involvement or extensive soft tissue disease refractory to surgery.
Synovial Sarcoma
These tumors are typically seen in young adults in the para-articular areas of tendon sheaths and joints. At least half occur in hte lower limbs, especially the knees. Surgery with adequate excision and adjuvant radiation therapy is indicated with or without adjuvant chemotherapy. Synovial sarcomas exhibit higher lymph node metastasis and better responses to chemotherapy than other histoloigc subtypes.
Peripheral Nerve Tumors
Neurofibroma
Solitary neurofibromas are small slow growing cutaneous or subcutaneous tumores not associated with NF1/vonRecklinghausen's disease.
Cutaneous neurofibromas are assocated with NF1/vonRecklinghausen's disease and are cutaneous neurofibromas of several types. They are associated with NF1, an autosomal dominant disease, featuring the following:
- café au lait spots;
- pigmented hamartomas of the iris
- neurofibromas of several types
Benign Schwannoma
AKA neurolemomas occur between the ages of 20 and 50. Common sites include head and neck, flexor surfaces of the extremities, and paravertebral retroperitoneum. They grow slowly but can reach large sizes in deep areas before becoming symptomatic. The tumor is encapsulated and diagnosis can be made by core needle or fine needle biopsy.
Malignant Peripheral Nerve Sheath Tumors
Also called malignant schwannomas, neurofibrosarcomas and neurogenic sarcomas, they are associated iwth major nerves of the body wall and extremities. They typically affect adults in the third to fifth decades. Tumor cells are elongated with frequent mitoses in a hypocellular myxoid stroma. They are generally high grade and stain for S100. They arise from the nerve sheath.
A Triton tumor is a MPNT with rhabdomyosarcomatous features. Schwann cells may the beh source f these elements.
Most arise in the lower extremities and retroperitoneum. They are high risk sarcomas, and have similar risk (accounting for grade, size) as other unfavorable sarcomas. They are largely resistant to chemotherapy.
Clinical Presentation and Natural History
Natural History
Soft tissue tumors are benign, malignant or in between. Sarcoma histology is an important predictor of prognosis and clinical behavior. Liposarcoma histoloigc subtypes have different biology and patterns of behavior. Typically sarcomas are characterized by local invasiveness. Metastatic patterns are hematogenous with lymphatic involvment uncommon except in synovial, clear cell, angiosarcoma, rhabdomyosarcoma and epitheloid.
Soft tissue sarcomas present as a slow growing painless mass. Median period of detection of the lesion and presentation is about 4 months and generally diagnosis takes about a month. Pain, numbness, edema may result from invasion of bone or neurovascular bundles.
Soft tissue sarcomas can occur in any site thorugh the body. 41% are extremities with 29% in the lower extremities. 36% are intra-abdominal.
Soft tissue sarcomas compress normal tissue and form pseudo-capsules consisting of an inner rim of normal tissue surrounded by an outer rim of edema and reactive zone of new vessels. They are invasive and can invade muscles, nerves, vessels and fascial. They rarely extend into adjacent tissue compartments until very advanced. Local spread is facilitated by surgical violation of tissue planes. Tumors can give rise to satellite lesions.
Between 6 and 10% will have metastatic disease at diagnosis, primarily to the lungs (70%) which also account for about half of all recurrences. Bone, liver and skin are involved less than 5% of the time.
Liposarcoma and retroperitoneal sarcomas spread to the liver and peritoneum, but lung is still the second metastatic site.
For patients with small superficial extremity lesions, either high or low grade, evaluation of metastatic sites is less important and simple chest radiography is adequate. For patients with large high grade lesions, the risk of metastatic disease is significant and full metastatic workup is required.
Diagnostic Workup
History/Physical, CT/MRI of primary, plain film of primary, If myxoid liposarcoma, obtain CT of abdomen: Frequent metastases to retroperitoneum. MRI brain for alveolar type.
Biopsy: Incisional biopsy with special care to align biopsy with planned resection so it can be excised during the resection. Core needle biopsy is diagnostic 90% of the time. Excisional biopsy contaminates surrounding tissue. Biopsy should be performed at the institution doing the surgery.
Grade
Histologic grade is the most important prognostic factor for adult soft tissue sarcoma. The WHO pathologic featuers that define grade include:
- Cellularity
- Histologic type
- pleomorphism
- necrosis
- mitotic count
Lymphatics
Regional lymphatic spread is uncommon. Around 6% at diagnosis are found to have nodal involvement. Tumor grade correlates with the likelihood of lymphatic involvement:
| Grade 1 | 0% |
| Grade 2 | 2% |
| Grade 3 | 12% |
There are certain histoloigc subtypes that more readily involve lymphatics. They are:
| Clear Cell Sarcoma | 28% |
| Epitheliod Sarcoma | 20% |
| Angiosarcoma | 23% |
| Rhabdomyosarcoma | 15% |
| Synovial Sarcoma | 14% |
Imaging
Imaging studies should be completed prior to any surgical procedures, including biopsy. MRI is preferred. Most tumors have intermediate to low signal on T1 weighted images and are bright on T2-weighted images. Lipsarcomas and angiosarcomas are high signal T1 images and are the exceptions. Gadolinium is not necessary and does not improve imaging resolution.
CT is used for detecting pulmonary metastases, although some centers use standard PA/Lateral radiographs. Selective CT for T2 and high grade extremity lesions may be more cost effective than blanket CT for all sarcomas. CT is widely used for imaging for conformal RT.
Bone scans are not useful in soft tissue sarcomas. Bone involvment, short of viscreal dissemination are rare. PET may provide metabolism and grade information but this has not been demonstrated conclusively. Response to treatment on serial PET scans has been shown in assessing 3 cycles of neoadjuvant adriamycin based therapy. In patients with an SUV decrease > 50% demonstrated a significantly longer time to recurrence at 38 months v. 18 months and better overall survival not reached v. 41 months.
Biopsy
Biopsy is a critical step in evaluating soft tissue sarcomas. Incisional biopsy is preferred for most soft tissue sarcomas with minimal surical manipulation. The incision is at risk for seeding and should be short, and oriented in the same direction as the surrounding musculature and situated so that it could be easily removed in future surgery without functional compromise.
Due to the potential for hematologenous spread, meticulous attention to hemostatis is essential to prevent dissemination by hematoma. Drains should not be routinely placed. If the lesion is small, (< 3 cm) and a 2 cm margin can be obtained, an excisional biopsy is sometimes performed. Core needle biopsy is increasingly used, particularly where pre-op RT or chemotherapy is contemplated for large, accessible tumors. Core needle biopsy and IHC are able to confirm teh diagnosis many times and give information of tumor grade. The CNB may be sufficient to initiate pre-operative therapy for high grade tumors and resect low grade tumors. FNA is not useful due to the loss of tissue architecture.
IHC staining is essential for full identification of soft tissue sarcomas. Frequently, it may not be completely clear that the disease is a sarcoma. Light mocroscopy, electron microscopy, IHC, cytogenetics and molecular genetics are widely used to establish diagnosis. Vimentin, cytokeratin, Desmin, actin, myoglobin, Factor VIII, CD34, CD31, S100 are commonly used.
Staging
The present AJCC Staging system (2010) incorporates a 2 tier grading system. The TNM staging is descriptive. Histologic grade and tumor size are the primary staging factors. T1/T2 tumors are substaged by tumor depth. Txa is superficial, Txb is deep. T1 is ≤ 5 cm. T2 is > 5 cm. Grades are G1/G2/G3. Staging based primarily on Grade, then on size. Grade 1 and ungraded are Stage I, Grade 2 and 3 are Stage II and Grade 3 large tumors are Stage III or node positive disease.
Survival rates are Stage I (T1/T2 Grade 1) 90% at 5 years. Stage II (T1 Grade 2/3 and T2/Grade 2) 81% Stage III 56%.
The AJCC staging system does not categorize by site of origin. Site of origin is prognostic with axial tumors predictive of worse outcomes.
| Grade | T1 | T2 | N1 | M1 |
|---|---|---|---|---|
| G1 | IA | IB | III | IV |
| G2 | IIA | IIB | III | IV |
| G3 | IIB | III | III | IV |
Prognosis
MSKCC and the French Federation studied populations with sarcoma. The French group studied extremity, head and neck, trunk, pelvis and retroperitoneum sites, while MSKCC studied extremity site characteristics. Tumor grade, size and deep location were the strongest prognostic factors for disease specific survival. The French Federation confirmed these three factors.
Distant Recurrence: Tumor grade, size and deep location were significant in both large studies. Leoimyosarcoma histology, local recurrence and no adjuvant chemotherapy also appeared to affect distant met risk to a lesser extent. Pisters found the following adverse features for local control in extremity sarcomas::
- Age > 50
- local recurrence at diagnosis
- microscopic surgical margin involvement
- fibrosarcoma
- peripheral nerve sheath tumor
Coindre found that poor surgery with local excision only, no adjuvant radiation therapy grade 3 and deep location were adverse predictors for local control.
Nodal metastases are rare and associated with poor survival, with 32% of patients with nodal involvment alive at 5 years.
Location influences survival due to influence on resectability of the lesion and adjacent structures limiting the ability to deliver adequate radiation doses. Sarcomas of the head and neck, mediastinum and retroperitoneum are more difficult to control locally due to critical organ proximity. Retroperitoneal tumors are often large at diagnosis resulting in lower survival rates for patients with these tumors as compared to extremity tumors.
Surgical margin influences local control. 91% 5 year disease free survival has been reported when margins are negative. with positive margins, the survival drops to 62%.
General Managment -- Surgery
There are four surgical categories used in the treatment of soft tissue sarcomas:
- Intralesional biopsy: Gross tumor remains and there is a potential for surrounding tissue contamination
- Excisional biopsy (shelling out): Tumor and pseudocapsule removed. There is potential for residual micro-aggregates and adjacent area contamination.
- Wide local excision: Resection of the tumor with a 2 - 3 cm rim of surrounding normal tissue, including any previous biopsy scar and surgical defect. Near normal functions are maintained by preserving muscles, nerves and bone.
- Radical local resection: The tumor and all compartmental structures are extirpated en bloc. Amputation is an example of this resection.
General Management -- Radiation Therapy
Radiation therapy goals are to enhance local control, preserve function and achieve acceptable cosmesis by contributing to organ preservation. Radiation therapy is combined with surgical approaches that use surgical margins of limited size to achieve these goals. The alternative to organ preservation is amputation.
Radiation therapy alone was originally limited to patients with locally advanced disease considered inoperable or recurrent or metastatic. Radiation doses were palliative. The Cade Technique was an organ preserving radiation treatment used to delay surgery (amputation) in patients suspect for developing lung metastases. Cade noted long term disease free survival for 6 of 22 patients treated with unresectable tumors treated with RT alone. Dose escalation to 64 Gy and neutron radiotherapy indicate that sarcomas may be cured by radiation alone if high doses can be employed.
Primary radiation should be used for patients with unresectble lesions because of anatomic location, medical inoperability and those refusing surgery.
General Management -- Conservative Surgery and Radiation
Cade obtained a 61% survival rate with conservative surgery and radiation therapy, compared with 27% with amputation with or without RT. An NCI study examined radiation and surgery. At risk areas received 50 Gy with a boost to 60 - 70 Gy to the tumor bed. All patients had post operative AC and high dose methotrexate. No patients recurred locally at 4 years 10 months. 4 of 27 patients with limb sparing relapsed locally. There was no difference in DFS and OS. The study concluded that limb-sparing procedures with RT are effectve for most patients with soft tissue sarcomas.
Pisters et al, in 1996 demonstrated the benefit of brachytherapy in enhancing local control with conservative surgical resection using brachtherapy (JCO 1996;14:859) and Yang showed a benefit with external beam radiation in 1998. (JCO 1998;16:197). O'Sullivan reported on a high rate of local control comparing pre-op v. post-op external beam radiotherapy.
Radiation Therapy Indications
Pre-operative, post-operative, intraoperative or brachytherapy have been used to combine radiation and surgery.
High Grade Tumors: Evidence suggests that both EBRT and Brachytherapy are equally effective for high grade tumors. EBRT appeared to be more useful for local control in low grade tumors in the post-operative setting. The timing of radiation therapy remains controversial.
An NCIC randomized study examined two approaches, preoperative v. post-operative radiation therapy in extremity soft tissue sarcoma for patients requiring combined modality. This trial closed early when a planned interim analysis showed a higher rate of acute wound complication with preoperative radiotherapy at 35% v. 17%. There was an unexplained overall survival advantage with preoperative radiation therapy, but no difference in disntant metastasis or disease free survival, suggesting there was an imbalance between the two trial arms. There was a trend toward Grade II or higher fibrosis (Acute Toxicity) (Late Toxicity)
To date, there has been no difference in local control between pre-op and post-op radiation therapy. For most small, resectable tumors, the preferred treatment is wide local excision followed by post-operative external beam radiation therapy. For large tumors (ie T2 > 5 cm) and deep tumors, for which surgical resection is difficult, IOERT followed by post-operative radiation therapy is preferred. IOERT acts as a boost and allows post-op EBRT dose to be reduced, with the potential for decreased fibrosis.
Low Grade Tumors: For small, low grade tumors the role of radiation is controversial. A small randomized study and at least one retrospective study sugests a local control benefit with the addition of post-op RT in larger tumors (T2, > 5 cm) with close surgical margins. Other studies indicate in well selected patients, RT can be omitted without compromising local control. Post-op radiation is not typically recommended for small lesions with wide local excision and widely negative margins. Many of these patients are cured with surgery alone. Radiation therapy is used in patients with postive or close margins or in those with large tumors where local recurrence would require amputation.
Per DeVita (p. 1763), All patients with lesions larger than 5 cm should be considered for adjuvant radiation as a proven method of limiting local recurrence, however, judicious application based on risk/benefit ratio should be emphasized.
Radiation Therapy Techniques
Radiation therapy must be closely coordinated with the interdisciplinary team. Treatment planning mandates comprehensive anatomical knowledge. The target volume should be planned pre-operatively from imaging studies and physical examination. Surgeons should be requested to place clips at the tumor bed margins and the outer margins of the surgical field to fully identify the tumor location in relation to the neurovascular bundles and bone. Pathology should be reviewed for margin status, presence of satellite nodules and location of residual disease. Radiation therapy should be given within 2-4 weeks post-operatively to allow sufficient wound healing time. If a skin graft or muscle flap is used in reconstruction then radiation should be delayed until 6 weeks post-op to insure graft success. If radiation is delivered pre-op, then surgery should be delayed until 1 ½ and 3 weeks post-radiation.
CT guidance for treatment planning should be used in treating soft tissue sarcomas. Volumes:
- GTV: radiographically defined tumor. Peritomoral edema should be included.
- GTV-Post-op setting: All areas handled during surgery including scars and drain sites.
- CTV: generally, but not universally as follows: (MGH/MDA)
- 5 cm longitudinal margin for grade 1 tumors
- 7 cm longitudinal margin for grade 2/3 tumors (MSKCC)
- No attempt is made to cover the entire compartment.
The CTV is treated to 50 Gy with a reduced boost field to the GTV plus 3 - 4 cm. At PMH margins on the GTV are 5 cm longitudinally and 2 cm radially with ≥ 2 cm maring on the surgical scar and all drain sites, regardless of grade. There is no attempt to cover the entire compartment. Compensation (compensators or Field in Field) is used to improve dose homogeneity.
Nodes are not covered unless the histopathology is a variety that has higher risk of nodal disease:
- Epitheliod
- Clear cell
- Rhabdomyosarcoma (high grade)
- synovial sarcoma
- lymphangiosarcoma
Avoid full circumferential RT to a limb to reduce the risk of severe lymphedema, fibrosis with pain, and loss of function, requiring amputation. Spare as much of the uninvolved compartments as possible without sparing tumor bed. A portion of the circumference of uninvolved bone should be spared ot reduce risk of fracture. If a scar crosses the joint, try to spare some of the joint unless it was surgically violated. Bolus the scar to insure adequate dose, where the beam is not tangent to the scar. Feather the gaps where they are required on a weekly basis..
Radiation Dose
Sarcomas are not radio-resistant as was formerly thought. Sarcomas have similar radiosensitivity to epithelial cancers. NCI recommends post operative tumor dose of 63 Gy at 1.8 Gy/fraction. If there is gross residual disease 70 - 75 Gy is used. At Mass General, preoperative radiation is advoc ated for large tumors. 50 Gy at 2 Gy/fraction is used. A 2½ week recovery period is allowed before surgery. A post op boost of 15 Gy for microscopical positive margins is given and 25 Gy is used for gross residual disease. If adriamycin based chemotherapy was given, these doses are reduced by 10% and the start of radiation therapy is delayed until 3 - 4 days after drug administration. Doses to other than extremities is based on normal tissue dose tolerance and volume.
Brachytherapy
BT is used as boost or treatment of recurrences after surgical resection and for failures of prior external beam radiation therapy. Single planar implants are recommended to decrease morbidity. Catheters are loaded between day 6 and 14 to permit adequate wound healing if BT is monotherapy. Sources must not be loaded sooner than post operative day 6. Radioactive sources can be loaded sooner (at 2 days) after surgery if BT is a boost and the total dose is limited from brachytherapy to 20 Gy. 15 - 25 Gy at 40 - 50 cGy/hr are safe for boost treatments. 45 Gy over 4 - 6 days (EQD2 60 Gy EBRT) is used for definitive post-op RT or for treatment of recurrences.
Brachytherapy margins are 2 cm longitudinal and 1 cm axial with 1 cm implant needle spacing.
- Dose: 45 Gy at 40 cGy - 50 cGy/hr for 4 to 6 days (sole treatment)
- Dose: 15 - 20 Gy @ 40 cGy - 50 cGy/hr with External beam boost of 45 - 50 Gy.
- Usually 192Ir is used.
A randomized clinical trial was performed to determine brachytherapy role after complete resection. Patients were randomized to adjuvant brachtherapy or no further therapy. 10 year actuarial control rates were 81% (with brachytherapy) and 67% (no further treatment) favoring brachytherapy. The improvement in local control was limited to high grade, completely resected tumors. In this group, the difference was 89% and 64% favoring brachytherapy.
For low grade sarcomas, brachytherapy did not lead to an improvement in local control, recurrence rates were 22% without brachy and 27% with brachy. There appears to be a need for adjuvant external beam radiation in these groups.
The American Brachytherapy Society recommends against brachtherapy as sole modality treatment in the following circumstances:
- CTV cannot be adequately covered by the implant geometry
- Proximate critical anatomy is anticipated to prevent delivery of a meaningful dose
- Positive resection margins
- Skin involvement.
An additional indication for brachytherapy is for recurrences in patients who were previously irradiated and would otherwise require amputation to obtain good local control. Catton reported local control rates of 36% for patients treated with conservative surgery and no further RT. They reported 100% local control in patients treated with resection and re-irradiation using brachytherapy at median follow up of 24 months.
Special Problems
The preferred surgical approach is an en bloc resection to clear margins. PMH reported that the cause of positive margins appears to be an important influence on local control. Once cause of positive margins is an oncologically inadequate surgery in which positive margins may have been avoidable. When this is the case, positive margins can be considered a technical failure. Alternatively, positive margins may arise in anatomically adverse presentations in which locally advanced disease challenges the goals of conservative resection.
After adjuvant radiotherapy, patients with low grade liposarcomas and microscopically positive surgical margins have a low risk of local failure (4.2%). Similarly anticipated positive margins to preserve critical structures treated with adjuvant radiotherapy to sterilize minimal residual disease has a low risk of local failure of 3.6%.
Two cateogries of patients with positive margins are associated with higher risk of local recurrence:
- Patients who present after a pre-referral excision without adquate pre-operative staging or consideration of the need to remove normal tissue around the tumor.
- Those with unanticipated positive margins occuring during primary sarcoma resection.
These patients have recurrence rates of 37.5%. The importance of this observation is that it seems to be possible to appropriately evaluate and anticipate resection with protection of critical adjacent anatomy, resulting in minimal microscopic residual burden that can be controlled with adjuvant radiotherapy.
Small Sarcomas
Treatment policy at MSKCC and PMH has been to omit adjuvant RT in patients with small tumors and adequate margins. It Surgical margin status at resection is important. Positive margins: LC5 is 56% v. 88% (negative margins). MDACC reported that the burden of residual tumor is important and adjuvant radiotherapy may not always be able to sterilize it. Treatment is recommended for tumors ≤ 5 cm if margins are positive. PMH found a significantly higher rate of local recurrence in patients who were treated after unplanned excision on the outside compared to patients treated exclusively at PMH.
STS of the Hands and Feet
Wide excision of hand and foot sarcomas are difficult due to the anatomical characteristics. MSKCC shoed with hand tumors ≤ 5 cm surival rates were lower than other distal extremety sites. Radiotherapy has been shown to be tolrated and should be considered. Special attention to techniques to preserve function and minimize complications. Patients who have definitive wide excisions or re-excisions had LC10 of 88%; significantly better than those who did not have re-excisions. There does not appear to be a survival benefit from immediate amputation. 88% of survivaors did not require amputation and were able to return to work and ADL with minimal to no functional limits.
.
Outcomes
Surgery Alone
.Surgery alone results in excellent local/regional control for select patients who have low grade tumors. Fabrizio reported no local failures/distant relapses and 96% survival with low grade tumors treated with surgery alone at nearly 5 years. Geer reviewed 117 cases with T1 tumors treated surgically with 92% local control rate. University of Chicago used wide local excision to treat subcutaneous sarcomas of the extremity with wide radial margins and resection of fascia. There were no local recurrences. Alektiar reviewed 204 patients at MSKCC for Stage IIB (high grade, tumor > 5 cm) with negative margins. 43% were treated with adjuvant radiotherapy, 17% had chemotherapy. There was no difference in this well balanced population in 5 year local control at 84% v. 80% with the addition of radiation therapy. The role of radiotherapy in small high grade tumors is uncertain.
Preoperative RT
Nielsen resimulated 26 patients who had received pre-operative RT in the post-op settings. Pre-op margins were 5 cm for grade 1/2 disease and 7 cm for grade 3 sarcomas. The same margins were employed in the post op setting around the surgical bed. The pre-op volume was 241 cm3 v. 391 cm3. More joints were included in post-op volumes.
Pre-op RT iafter wide local excision at MDACC with 89% > 5 cm, at 17 months, local control was 90% and DFS was 61%.
Herman Suit found a local control advantage for pre-op RT over post-op RT especially for large lesions. Local control for lesions > 15 cm were 56% for PORT and 86% for Pre-op RT.
RTOG investigated combined chemo/RT with a number of regiments, RT doses and fractionation schemes. Ultimately they found that 2 courses of high dose ifosfamide followed by 28 Gy doxorubicin, CDDP and conservative surgery improved local control rate to 95%. Treatment induced pathologic necrosis after pre-op therapy appeared to be an independent predictor of both local recurrence and overall survival in this group of 496 patinets. Patients with less than 95% necrosis were 2.5 x more likely to develop local recurrence and 1.9 x more likely to die fo their disease as compared with those with greater than or equal 95% pathologic necrosis or a complete response.
Postoperative Radiation
MDACC reported the largest post-op series with 300 patients of the extremities, head and neck, and retroperitoneum treated with conservative excision followed by radiation therapy to a total dose of 60 - 75 Gy in 6 - 7½ weeks. No attempts were made to cover the muscle or the anatomic compartment. Local recurrence rates was 20% for extremity, 23% for head and neck, 38% for abdominal. One third failed beyond the margins of the treated field. Local control did not change with a 10 Gy dose reduction later in the study. 82% received > 55 Gy. With surgery and post-op RT local control was 90% and RFS at 5 years was 68%. This was found to be superior to surgery alone and comparable to radical surgery.
Comparision of Sequalae of Preoperative v. Postoperative Radiation Therapy
| PREOPERATIVE RADIATION |
|
| POSTOPERATIVE RADIATION |
|
A Canadian Sarcoma Group randomized trial demonstrated pre-operative RT doubles the risk of early acute wound complication. This observation seems to apply almost exclusively to lower limb lesions. Post operative volumes are larger and associated with higher doses which impact late tissue morbidity. Post radiation sequalae in the post-op RT setting include increased tissue fibrosis and edema, late bone fracture and larger volumes.
This study defined acoute wound complication criteria as:
- secondary wound surgery
- hospitalization for wound care
- need for deep packing/prolonged dressings which occur within 120 days of resection.
Preoperative RT has not been subjected to randomized comparision against surgery alone. The Canadian Sarcoma Group trial at 3.3 years median follow up in a randomized controlled trial reported identical local control at 93% and a small advantage in overall survival in favor of pre-opeartive radiotherapy which was significant at 3 years but not at 5 years. The 5 year results were:
| Preop RT | Postop RT | |
|---|---|---|
| Local Control | 93% | 92% |
| mets relapse free | 67% | 69% |
| Recurrence free survival | 58% | 59% |
| Cause specific survival | 78% | 73% |
In this trial, only resection margins were significant for local control. Tumor size and grade were the only significant factors for metastatic relapse, OS and CSS. Grade was the only consistent predictor of recurrence free survival.
Retroperitoneum
Two studies examined retroperitoneal sarcoma: PMH and MDAnderson. PMH used a median pre-op dose of 45 Gy at 1.8 Gy/fraction to volumes exceeding 7 liters. Brachytherapy used postoperatively at PMH was associated with high toxicity and did not appear to contribute to enhanced tumor outcomes. MDACC reported similar findings.
Definitive Radiation Therapy
Every effort should be made to attempt resection. Definitive radiation is, by nature, palliative. Joel Tepper and Herman Suit reported on definitive treatments (64 - 66 Gy EBRT) that local control rates at 5 years were 33% and survival rates 22%. Local control was better for small tumors (≤ 5 cm) at 87% v. 45% (5 - 10 cm) v. 9% (> 10cm). Sarcomas appear to be dose sensitive with worse 5 year outcomes at doses < 63 Gy. Complications increase beyond about 68 Gy.
Chemotherapy
High risk soft tissue sarcomas are those of large size, deep location and high grade. They present a significant risk of local-regional recurrence and distant metastases, primarily the lung for extremities, and liver and peritoneum for liposarcomas and retroperitoneal sarcomas. MGH studied chemoradiation in patients with localized, high grade, large (> 8 cm) soft tissue sarcomas of the extremity. 3 cycles of mesna, adrianycin, ifosfamide and dacarbazine, with two 22 Gy courses of RT to a total pre-op dose of 44 Gy with an additional 16 Gy boost for microscopically positive margins, total dose with boost of 60 Gy. Local and systemic toxicity included significant, expected wound healing complications in the lower limbs in 29%, one death due to marrow dysfunction associated with chemotherapy. A multicenter study demonstrated significant toxicity with 5% having fatal grade 5 toxicities of myelodysplasia and sepsis.
Adjuvant/NeoAdjuvant Chemotherapy
Up to half of patients with primary non-GIST sarcomas with adequate local/regional control will develop distant metastases. Most of these are to the lung (extremities) and liver (abdominal). Isolated lung nodules can be resected with good effect. Multiple studies of adjuvant chemotherapy for STS have been perfomred, with anthracyclines showing efficacy and used in most of these stufies. Most studies have accrued small numbers and lack statistical power to detect small changes in overall survival. From these studies, if there is a benefit at all, it is small. Pre-operative chemotherapy in Ewing's Sarcoma and osteosarcoma (pediatric sarcomas) has been successful.
Neoadjuvant chemotherapy, based on pediatric chemotherapy in Ewings and osteosarcoma has been extended to adult soft tissue sarcoma treatment. Treating with chemotherapy prio to surgery leaves primary vasculature intact for drug delivery, and can potentially guide post-operative treatment based on phathologic features.
GOG Adriamycin Study for Uterine Sarcoma
The GOG studied 225 patients with Stage I/II uterine sarcomas treated with or without Doxorubicin 60 mg/m2 q 3 weeks x 8 cycles v. no chemotherapy. Radiation therapy was at the discretion of the treating physician for local/regional control. There was no difference between the two groups in DFS or OS. Radiation did not affect OS but did reduce vaginal relapse.
Scandinavian Sarcoma Group
This is the largest study of single agent doxorubicin in soft tissue sarcomas. 240 patients were treated with surgery and optional adjuvant radiation. They were then randomized to doxorubicin q 4 weeks x 9 cycles v. no further treatment. Chemotherapy was started within 6 weeks of surgery or within 10 weeks of radiation. At median follow-up of 40 months there was no difference in LC, DFS or OS.
EORTC Combined Agent: Cyclophosphamide/Vincristine/Doxorubicin/Dacarbazine q 28 days x 8 cycles
DFS and LC were better in the chemotherapy arm, but OS was not significantly different. Radiotherapy was given if surgical margins were less than 1 cm. Improvement in local recurrence rates wwas limited to patients with head, neck and trunk sarcomas. There was no difference observed in extremity sarcomas.
Italian Sarcoma Stugy Group
Anthracycline/Ifosfamide Adjuvant or Neoadjuvant chemotherapy was examined in 104 patients randomly assigned to no chemotherapy or ifosfamide/epirubicin chemotherapy. The trial was closed early dur to primary endpoint of improved DFS reached. At median follow-up of 38 months OS in themotherapy arm was 72% v. 55% in the control arm. Withh longer follow-up, OS5 and DFS no longer reach statistical significance. This study has been used as a rationale for ifosfamide/adriamycin in the adjuvant setting.
NCIC/EORTC Phase II Neoadjuvant AI (Adriamycin/isfosfamide)
OS and DFS were not significanlty different with OS 64% at 5 years v. 65% with chemotherapy. This was a reduced dose intensity study compared with prior (Italian) studies.
Austrian Dose Intensification Study AID (Adriamycin, Isfosfamide, Dacarbazine)
OS and RFS were not different at mean follow-up of 41 months.
The Sarcoma Meta-Analysis
14 studies accrued before 1992 with 1568 patients and median follow-up of 9.4 years stratified by trial: DFS10 was improved from 45 to 55% and was statistically significant. Local DFS10 favored chemotherapy but OS was not statistically significant. The largest difference in OS was found in patients with extremity sarcomas.
Any impact on OS of adjuvant or neoadjuvant chemotherapy appears to be small, if any benefit at all. Pediatric soft tissue Ewing's Sarcoma and pediatric rhabdomyosarcoma do benefit from chemotherapy. Any impact on overall survival of adjuvant chemotherapy appears to be small.
Non-Extremety Sites: Retroperitoneal or Visceral Sarcomas
Clinical Presentation
Most present with asymptomatic abdominal mass. Diagnosis may be clear from imaging and resection is sometimes undertaken without biopsy. Neurologic symptoms related to an exapnding retroperitoneal mass were found in about 1/3 of the patients. Differential diagnosis includes GCT, lymphoma or primary retroperitoneal tumor (adrenal). Most are mesenchymal tumors.
Retroperitoneal and visceral sarcomas are about 30% of all sarcomas. Retroperitoneal sarcomas are generally:
- 40% liposarcoma
- 25% leiomyosarcoma
- Malignant peripherphal nerve sheath tumors
- fibrosarcoma
Visceral sarcomas are generally
- Gastrointestinal stromal tumors (GIST)
- leiomyosarcoma
- desmoid tumors
About 55% of retroperitoneal liposarcomas are low grade with 40% showing de-differentiated high grade features. Primary surgical resection is the dominant therapy. Many tumores involve the retroperitoneum requiring full evaluation of renal function especially in the contralateral kidney, to permit nephrectomy when necessary. It is clear the complete surgical resectionis the primary factgor in outcomes. Once an R0 resection is obtained, then the predominant factor is grade of the lesion.
the use of debulking for recurrent lesions is of limited long-term survival. More extended resections do not improve local recurrence or survival. The degree of palliation achievable is a clinical judgement and unless palliation can be achieved, reserving surgery for those whom complete resection is at least possible if not probable is desired.
In retroperitoneal liposarcomas, there is some evidence that incomplete resection may be associated with prolonged survival.
MSKCC reported from 1982 - 1987 half of retroperitoneal patients presented with liposarcoma and 29% presented with leiomyosarcoma. 65% underwent complete resection and half could not have a complete resection. Local recurrence was 40-50% despite complete resection. Local recurrence is an issue for both high grade and low grade sarcomas.
Radiation therapy is limited due to the proximity of radiation sensitive organs in the retroperitoneum, thus restricting RT to modest doses. Ivy Petersen reported on 87 patients treated with IORT supplemented by external beam RT. Doses were 20 Gy (IORT) followed by 35-40 Gy EBRT v. EBRT alone to 50 - 55 Gy. There was a significant improvement in local control with IORT. There was no impact on survival.
UAB reported the feasibility of using IMRT to selectively boost regions pre-operatively at high risk of positive margin. The entire GTV was treated to 45 Gy followed by a boost to the area judged to be at risk for positive margin at the time of resection to a total dose of 57.5 Gy. Minimal toxicity was noted, 11/14 patients had complete resection to negative margins.
There are no prospective data evaluating this approach and surgical management is the standard of care, at present.
Imaging
CT imaging is the primary mode of evaluation and should include the liver as the most likely site of visceral metastasis.
Head and Neck Sarcoma
STS of the head and neck in adults are rare representing about 1% of all head and neck cancers and 10% of all STS. The present as a painless masswith a preponderance of angiosarcoma of the scalp. Surgery is the primary treatment with the goal of R0 resection. They are not readily amenable to wide local excision due to anatomical constraints. Local recurrence can be the cause of death and radiation is used frequently as adjuvant therapy. Angiosarcomas tend to infiltrate widely and metastasize to lymph nodes. This makes WLE difficult. Morrison reported on 14 patients with angiosarcoma of the head and neck treated with radiation with or without surgery: OS-5 and distant metastases free survival were 29% and 37%. The 5 years above the clavicle local control rates were 24% with definitive RT compared to 40% witth adjuvant RT.
Complications of Treatment
Wound Complications
Radiation and chemotherapy both increase wound complications if given within 7 days either way of the procedure. MDACC reported on surgical morbidity of radical surgery in patients receiving pre-op chemotherapy v. no pre-op chemotherapy and found the most common complications were wound infections but the incidence of surgical complications was no different for patients undergoing pre-operative chemotherapy in both extremity sarcomas and in retroperitoneal/visceral sarcomas.
Quality of Life
Adjuvant radiation impact on function and quality of life has been extensively studied. there are transient deficits in limb strength, edema and range of motion. MSCKK studied patients with rigorous physcofunctional testing and found no significant differences in functional outcome between brachytherapy and no brachytherapy groups. There was a correlation between the volume treated to 55 Gy or higher and poorer functionla score, strength, fibrosis and skin changes.